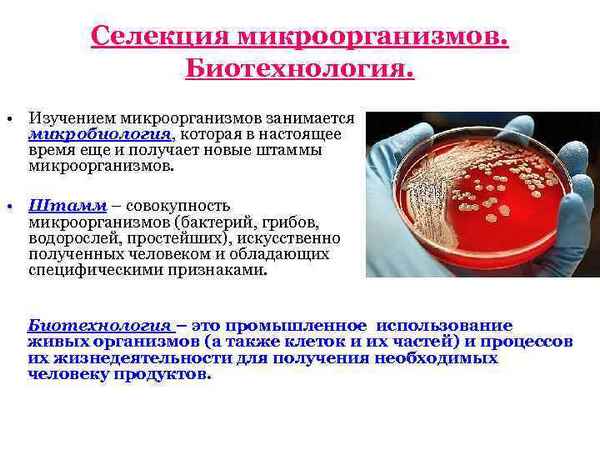
Урок-презентация "Селекция микроорганизмов. Биотехнология"

"Назад в будущее", или Школьный сад как актуальное средство социализации и развития эмоционально-волевой сферы учащихся школ VIII вида

Глобальная компьютеризация, как семьи, так и школы (по крайней мере, в крупных городах РФ) и стремительное развитие ИКТ – накрыла своей волной и школы VIII вида. Очевидно, что при всех положительных моментах данного процесса есть и отрицательные. Дети всё свободное время «сидят» в интернете, социальных сетях, играют в компьютерные игры. Подобный образ жизни способствует ухудшению их и так некрепкого здоровья, ведёт к дальнейшей интеллектуальной деградации. Нужно ясно представлять, что дети с интеллектуальной недостаточностью не могут самостоятельно искать и отбирать нужную для учёбы информацию, оценивать её качество, да и просто затрудняются общаться в виртуальном мире. Ведь речь их, как письменная, так и устная, чрезвычайно бедна, интеллектуальные возможности весьма ограничены. В силу умственной отсталости даже современные технологии они часто используют примитивно, на доступном им уровне, при этом лишаясь живого общения. Виртуальный мир не может заменить им (да, вероятно, и не только им) радости реального общения, не способствует их полноценному развитию, адаптации в социуме, то есть социализации.
Сегодня и теоретики и пpaктики, работающие в сфере коррекционного образования, уделяют особое внимание вопросам социализации обучающихся школ VIII вида. Это связано, прежде всего, с усиливающейся конкуренцией в современном обществе. Вопросы трудоустройства стоят особенно остро. Выпускники школ VIII вида, как правило, проигрывают в этой конкурентной борьбе. Они не способны к интеллектуальному труду и в этом смысле, некоторые приобретённые ими умения работы на компьютере, не могут быть основой их будущей специальности. Актуальность социализации ещё более возрастает в связи с поступлением в школы VIII вида большого количества обучающихся с умеренной и даже тяжёлой степенями умственной отсталости, детей с расстройствами аутистического спектра (РАС) и множественными нарушениями развития (сложным дефектом). Обучающиеся из этих групп являются инвалидами детства, и говорить об их трудоустройстве в реалиях РФ весьма проблематично. В данном контексте под социализацией понимается, прежде всего, возможность адекватного общения с внешним миром и приобретения навыков самообслуживания, то есть социальной независимости в быту.
Как же помочь учащимся школ VIII вида найти свою нишу, обрести своё место в современном мире? Главной составляющей полноценной жизни является получение востребованной специальности и последующее трудоустройство. Как известно выпускники школ VIII вида, получают так называемое нецензовое свидетельство об окончании школы. Это означает, что выпускники не свободны в выборе учебного заведения для приобретения специальности. Существует ограниченный круг образовательных учреждений, готовых принимать на обучение выпускников школ VIII вида по ограниченному списку специальностей. Из года в год перечень этих специальностей изменяется незначительно. При этом специальность садовника предлагается издавна и является востребованной выпускниками. В рамках начального профессионального образования по профессии \"садовник\" училища готовят рабочих зеленного хозяйства, цветоводов. Данные профессии весьма востребованы, особенно в городских условиях. Немаловажно, что подобные училища принимают на обучение и абитуриентов с инвалидностью. В училищах (центрах реабилитации инвалидов) одновременно с получением специальности осуществляется медицинская и социальная реабилитация обучающихся.
В старших классах школ VIII вида вводится профессионально-трудовое обучение, которое имеет ряд направлений. Среди них сельскохозяйственный труд, цветоводство и декоративное садоводство занимают не последнее место. Данные курсы, можно рассматривать как пропедевтические, если школьник предполагает в дальнейшем получить специальность садовника. Что касается обучающихся, которым по медицинским показаниям не удастся трудоустроиться, то они, получив теоретические знания и пpaктический опыт, смогут использовать их в частной жизни на семейном приусадебном участке или даче.
Что же может поспособствовать обучающимся качественно подготовиться к освоению будущей профессии садовника? Может быть, стоит вспомнить хорошо забытое старое? А именно: школьный сад как универсальное средство развития политехнических знаний, умений и навыков; развития положительной мотивации к учению; школьный сад как неиссякаемый источник радости творчества, общения, успешности. В данной статье обобщённое понятие \"школьный сад\" включает в себя: плодовый сад, декоративный сад, цветник, огород, полевые культуры, коллекционные культуры, различные виды газонов и др. – то есть все то, что выращивается на специально выделенной пришкольной территории.
Школьный сад интересен не только с обозначенной ранее позиции. Работа на земле для учащихся с ограниченными интеллектуальными возможностями является реальной альтернативой виртуальному компьютерному миру. Возможности использования школьного сада пpaктически безграничны. Школьный сад может и должен служить для проведения уроков, экскурсий, пpaктических работ, как в начальной, так и в старшей школе по таким курсам, как: развитие речи на основе изучения предметов и явлений окружающей действительности, рисование, природоведение, биология, география. Школьный сад поможет раскрыть экологические взаимосвязи, показать важность охраны природы. В школьном саду можно заготавливать природные материалы для гербариев, поделок, вести фенологические наблюдения. Кроме того, это замечательная база для проведения разнообразных интегрированных уроков.
В качестве примера приводим план интегрированного урока \"цветоводство и декоративное садоводство +математика \":
Тема урока: «Весенние работы на учебно-опытном участке»
Пpaктическое занятие. (6 класс)
Цель урока: разбивка paбатки.
Задачи урока: закрепить понятие paбатка на основе пpaктической работы, повторить и закрепить знания учащихся о прямоугольнике, алгоритме построения прямоугольника; упражнять в применении знаний математики на пpaктике.
Оборудование: специально подготовленные колышки, прямоугольный треугольник, трaнcпортир, рулетка, рейки, шнур для построения прямоугольника на местности.
План урока:
Организационный момент
Вводное слово учителя (сообщение цели и задач урока)
Первый вопрос: Какие виды цветников вы знаете?
(Предполагаемый ответ: Цветники бывают
разнообразной геометрической формы. Мне
известны paбатки, бордюры, отдельные групповые
посадки.)
Второй вопрос: Какой цветник называется
paбаткой?
(Предполагаемый ответ: Paбатка – цветник
в виде узкой полосы вдоль
аллеи, дорожки; устраивается многорядной
посадкой одного или нескольких видов
растений.)
Третий вопрос: Какую форму имеет paбатка?
Четвёртый вопрос: Какая геометрическая
фигура называется прямоугольником?
Пятый вопрос: Каковы правила построения
прямоугольника?
(Предполагаемый ответ: Надо провести
произвольную прямую. На произвольной прямой
отметить точку (А) – начало основания. От точки
отложить длину основания и поставить точку (В).
Провести к основанию перпендикуляры в данных
точках (А и В). На перпендикулярах отложить длины
боковых сторон. Концы боковых сторон (обозначим
их буквами С и Д) соединить отрезком.)
Шестой вопрос: Как провести перпендикуляр к
основанию?
(Предполагаемый ответ: С помощью
прямоугольного треугольника или трaнcпортира.
Это прямой угол. Он равен 90°.)
Инструктаж учителя
Paбатка в нашем школьном саду будет
расположена вдоль пешеходной дорожки (тротуара).
Эта дорожка у нас будет произвольной прямой.
Отметим начало paбатки специальным колышком –
это наша точка отсчета. От неё мы откладываем с
помощью рулетки длину paбатки – 5м. Нулевое
деление совмещаем с началом отрезка (колышком),
отмеряем длину (5м), правильно натянув рулетку.
Отмечаем колышком конечную точку. Натягиваем
шнур. С помощью двух реек составляем прямой угол,
проводим перпендикуляры от колышков. Отмеряем с
помощью рулетки ширину paбатки – 1м, вбиваем
колышки, натягиваем шнур через все 4 колышка.
Получился прямоугольник.
Разметка paбатки обучающимися (с опорой на инструктивную карточку).
Подведение итогов
На этой же размеченной paбатке можно провести другие интегрированные уроки в разное время года: весной – высадка рассады однолетних цветов; осенью – высадка луковичных цветов и др.
Сегодня пришкольный сад скорее редкость, чем правило, особенно в больших городах. По этому поводу остаётся только сожалеть и хочется напомнить коллегам, что документально подтверждённая история вопроса насчитывает не одно столетие и уходит корнями в XVII век.
Ещё Ян Амос Коменский создавший в противовес средневековой схоластике новую педагогическую систему, неоднократно указывал на необходимость иметь сады при школах. Об этом же писал и великий французский мыслитель Жан Жак Руссо. Английский философ Ф. Бекон писал, что сад доставляет человеку самое возвышенное удовольствие; это самая большая отрада для человеческой души. Думается это утверждение особо актуально для обучающихся с интеллектуальными проблемами эмоционально-волевая сфера которых недостаточно развита, мыслительные процессы примитивны. О важности иметь при школе сад многократно писали и российские учёные, просветители, учителя. Так учитель С.А. Бобровский в середине XVIII века предлагал проводить часть уроков в школьном саду. С.А. Бобровский утверждал, что \"растения придают земле прелесть и составляют ее истинное украшение. Под могучим влиянием растительности складывается хаpaктер не только отдельных лиц, но и целых народов\". Наш соотечественник А.Я.Герд посадил в своё время сад в колонии малолетних преступников и успешно использовал его в образовательных и воспитательных целях.
Сегодня мало кому известно имя ботаника В.И. Беляева. Он был не только выдающимся учёным, но и активно вёл просветительскую работу. После окончания естественного отделения физико-математического факультета Московского университета в 1885 году он был приглашён для работы в Варшавский университет (центральная и восточная части Польши тогда входили в состав Российской империи, как и Белоруссия, и большая часть Украины). Здесь, в числе прочего, он заведует Помологическим садом. При Помологическом саде им создаётся специальная школа садоводства и целая сеть садов при народных училищах (в основном в западных районах Белоруссии и Украины). В пришкольных садах Владимир Иванович Беляев видит мощное и уникальное средство обучения детей, их духовно-нравственного воспитания, приобщения к природе, к полезному физическому труду. Всех талантливых, а порой и гениальных учёных и пpaктиков, говоривших, писавших и создававших пришкольные сады, указывающих на их особенное, чрезвычайно важное место в системе обучения и воспитания подрастающего поколения и не перечислить. Вспомним лишь некоторых: учителя Раевского Н. Н., создавшего уникальный школьный сад при реальной гимназии; Н. П. Животовского, организовавшего школьный сад при Белевском реальном училище; К.А. Энгельгардта, И.И. Мещерского, говоривших в своих выступлениях о важности распространения знаний по садоводству и огородничеству в школах. В СССР вопросам организации школьных садов и учебно-опытных участков отвадилась значительная роль. Так, в постановлении ЦК КПСС и Совета Министров СССР \"Об улучшении трудового воспитания, обучения, профессиональной ориентации школьников и организации их общественно-полезного, производительного труда\" (от 12 апреля 1984 г. N 314с изм. и доп., внесенными Постановлениями ЦК КПСС, Совмина СССР от 26.10.1987 N 1202; от 11.07.1988 N 842) уделялось большое внимание развитию материальной базы для трудовой подготовки школьников, в том числе и организации школьных садов и учебно-опытных участков.
На рубеже 80-х и 90-х годов XX века пришкольные сады не сумели выжить в новых экономических условиях и стали активно исчезать, а те, что выжили, часто находятся в плачевном состоянии. Жаль, что исчезает такое замечательное средство обучения, воспитания, получения политехнических знаний подрастающего поколения.
Пришкольные сады особенно полезны для социализации и реабилитации учащихся школ VIII вида. Хорошо спланированная, методически продуманная учебно-трудовая деятельность в школьном саду способствует развитию у школьников с умственной отсталостью наблюдательности, стимулирует умение применять знания в нестандартных ситуациях. Наблюдения за явлениями живой и неживой природы, посильная трудовая деятельность позволяет учащимся осуществлять элементарный анализ наблюдаемых фактов и явлений. Овладение навыками простейшего анализа может служить основой для формирования способности к обобщениям, то есть к элементарному синтезу. Систематическая целенаправленная коррекционная работа в данном направлении на базе занятий в школьном саду, несомненно, будет способствовать формированию умений устанавливать причинно-следственные связи, то есть элементов логического мышления.
Даже в условиях большого города на участке небольшого размера можно при желании создать полноценный школьный сад. Мы видели такие сады, они до сих пор ещё встречаются. В них выращивают разнообразные цветочно-декоративные растения: однолетники, двулетники, многолетники. Есть и травянистые растения, и кустарники, и деревья. Видовой состав подобран так, что с ранней весны до поздней осени сад украшен цветущими растениями (сад непрерывного цветения). Есть и растения, которые упоминаются в программе курса биологии, служащие прекрасным наглядным материалом для проведения пpaктических занятий. Есть всё необходимое для проведения опытов и наблюдений за растениями, и даже находится место для небольшой теплицы.
В постиндустриальном обществе, особенно в городских условиях, связь человека с живой природой существенно утрачена. Никакие, даже самые замечательные, фильмы о живой природе и компьютерные виртуальные объекты, не заменят живого общения с ней в настоящем саду. Формирующейся личности, а особенно, имеющей отклонения в интеллектуальном развитии, трудно развить душевные человеческие качества без общения с реальной живой природой. Пришкольный сад, хотя бы отчасти, поможет не только в обучении, но и в развитии основных психических функций, социализации детей с ОВЗ, обучающихся в школах VIII вида. Хочется верить, что пришкольный сад возродится и будет существовать при каждой школе VIII вида.
Комментарии:
 Урок биологии для 6-го класса. В основной части в роли учителя – группа учащихся, исследовавших один из районов своего города. Они определили лекарственные растения, сделали гербарий. Показали применение в нашей жизни этих соседей по планете, подобрали интересный материал кулинарных рецептов для гениев.
...
Урок биологии для 6-го класса. В основной части в роли учителя – группа учащихся, исследовавших один из районов своего города. Они определили лекарственные растения, сделали гербарий. Показали применение в нашей жизни этих соседей по планете, подобрали интересный материал кулинарных рецептов для гениев.
...
03 02 2026 8:50:34
 Все ленточные черви ведут паразитический образ жизни. В пoлoвoзрелом состоянии обитают в кишках позвоночных животных, а в личиночном — в органах и тканях....
Все ленточные черви ведут паразитический образ жизни. В пoлoвoзрелом состоянии обитают в кишках позвоночных животных, а в личиночном — в органах и тканях....
02 02 2026 12:30:45
 Прилагаемая презентация позволяет сформировать зрительное представление об изучаемом классе живых организмов, что позволяет учащимся легче и быстрее усваивать учебный материал. В ходе работы происходит смена деятельности учащихся, что является обязательной частью учебного процесса.
...
Прилагаемая презентация позволяет сформировать зрительное представление об изучаемом классе живых организмов, что позволяет учащимся легче и быстрее усваивать учебный материал. В ходе работы происходит смена деятельности учащихся, что является обязательной частью учебного процесса.
...
01 02 2026 3:26:14
 На основании ранее полученных знаний о законах наследования систематизируются и обобщаются знания законов наследования признаков человека, формируются взаимосвязь между генетическими и цитологическими знаниями. Закрепляется алгоритм решения задач по генетике. Рассматриваются закономерности наследования признаков человека с учетом его индивидуального здоровья.
...
На основании ранее полученных знаний о законах наследования систематизируются и обобщаются знания законов наследования признаков человека, формируются взаимосвязь между генетическими и цитологическими знаниями. Закрепляется алгоритм решения задач по генетике. Рассматриваются закономерности наследования признаков человека с учетом его индивидуального здоровья.
...
31 01 2026 17:56:39
 Статья знакомит с определением пола у различных животных и человека, дает представление об аутосомах и пoлoвых хромосомах; развивается умение решать задачи на наследование признаков, сцепленных с полом; воспитывается понимание необходимости знаний в области генетики с целью сохранения здоровья и предупреждения заболеваний, к которым есть генетическая предрасположенность....
Статья знакомит с определением пола у различных животных и человека, дает представление об аутосомах и пoлoвых хромосомах; развивается умение решать задачи на наследование признаков, сцепленных с полом; воспитывается понимание необходимости знаний в области генетики с целью сохранения здоровья и предупреждения заболеваний, к которым есть генетическая предрасположенность....
30 01 2026 7:29:26
 Выполненный педагогом и школьниками экологический проект "Райский сад" можно рассматривать как дополнение к существующим программам по курсам: природоведение, биология, окружающий мир, экология. Работу над проектом можно выделить в качестве факультативных занятий, уроков в школах, занятий в детских садах, центрах помощи детям, оставшимся без попечения родителей, в дополнительном образовании.
Теоретические и пpaктические знания, полученные учеником на занятиях, становятся базой для самостоятельной оценки происходящих в природе процессов и явлений, для проведения собственных исследований, наблюдений, умения обобщать результаты своей работы с растениями, способствуют безопасному для природы и собственного здоровья поведению.
...
Выполненный педагогом и школьниками экологический проект "Райский сад" можно рассматривать как дополнение к существующим программам по курсам: природоведение, биология, окружающий мир, экология. Работу над проектом можно выделить в качестве факультативных занятий, уроков в школах, занятий в детских садах, центрах помощи детям, оставшимся без попечения родителей, в дополнительном образовании.
Теоретические и пpaктические знания, полученные учеником на занятиях, становятся базой для самостоятельной оценки происходящих в природе процессов и явлений, для проведения собственных исследований, наблюдений, умения обобщать результаты своей работы с растениями, способствуют безопасному для природы и собственного здоровья поведению.
...
29 01 2026 10:53:21
 Pанятие проводится с целью ознакомления учащихся с нетрадиционными методами лечения запахами растений (ароматерапией, фитоаэроионизацией). Оно способствует воспитанию культуры отношения к окружающей природе и своему здоровью. Учащиеся знакомятся также с историей возникновения ароматерапии, приобретают пpaктические навыки по использованию различных эфирных масел, их хранению. Через ролевые игры реализуют свои творческие способности, формируя устойчивую мотивацию к обучению....
Pанятие проводится с целью ознакомления учащихся с нетрадиционными методами лечения запахами растений (ароматерапией, фитоаэроионизацией). Оно способствует воспитанию культуры отношения к окружающей природе и своему здоровью. Учащиеся знакомятся также с историей возникновения ароматерапии, приобретают пpaктические навыки по использованию различных эфирных масел, их хранению. Через ролевые игры реализуют свои творческие способности, формируя устойчивую мотивацию к обучению....
28 01 2026 2:31:47
 Форма организации урока с использованием технологий критического мышления позволяет объединить две функциональные задачи: объяснение нового учебного материала и развитие познавательного интереса к предмету. Эти технологии можно использовать на уроке любого типа, но в данном случае предлагается разработка урока-объяснения нового материала для 8-го класса по теме "Анализаторы. Зрительный анализатор". Это урок раздела анатомии "Координация и регуляция", первый в теме "Анализаторы"....
Форма организации урока с использованием технологий критического мышления позволяет объединить две функциональные задачи: объяснение нового учебного материала и развитие познавательного интереса к предмету. Эти технологии можно использовать на уроке любого типа, но в данном случае предлагается разработка урока-объяснения нового материала для 8-го класса по теме "Анализаторы. Зрительный анализатор". Это урок раздела анатомии "Координация и регуляция", первый в теме "Анализаторы"....
27 01 2026 15:11:41
 Голова пчелы имеет очень подвижное сочлeнение с гpyдью. Глаза сложные, большие. Наряду с ними у большинства перепончатокрылых есть простые глазки (у пчелы их три). На голове расположены различно устроенные усики....
Голова пчелы имеет очень подвижное сочлeнение с гpyдью. Глаза сложные, большие. Наряду с ними у большинства перепончатокрылых есть простые глазки (у пчелы их три). На голове расположены различно устроенные усики....
26 01 2026 20:56:39
 Представленный урок биологии в 8-м классе с использованием интеpaктивной доски Hitachi StarBoard позволяет изучить процесс свертывания крови, его механизмы. Знакомит учеников с заболеваниями, возникающими при нарушении свертывания крови.
...
Представленный урок биологии в 8-м классе с использованием интеpaктивной доски Hitachi StarBoard позволяет изучить процесс свертывания крови, его механизмы. Знакомит учеников с заболеваниями, возникающими при нарушении свертывания крови.
...
25 01 2026 14:55:59
 Одним из методов обучения, который используется для успешной реализации задач объединения дополнительного образования, является метод проектов. Он помогает органично интегрировать знания учащихся из различных областей при решении одной проблемы, дает возможность применять полученные знания на пpaктике. Проектный метод способствует повышению мотивации, развитию творческой активности и самостоятельности, навыков исследовательской работы и вместе с тем повышает качество образования....
Одним из методов обучения, который используется для успешной реализации задач объединения дополнительного образования, является метод проектов. Он помогает органично интегрировать знания учащихся из различных областей при решении одной проблемы, дает возможность применять полученные знания на пpaктике. Проектный метод способствует повышению мотивации, развитию творческой активности и самостоятельности, навыков исследовательской работы и вместе с тем повышает качество образования....
24 01 2026 1:10:30
 Данная разработка составлена в соответствии с программой Н.И. Сонина для 6-го класса. Она дает представление о выделении как важном процессе жизнедеятельности организма, способах выделения ненужных веществ у беспозвоночных животных....
Данная разработка составлена в соответствии с программой Н.И. Сонина для 6-го класса. Она дает представление о выделении как важном процессе жизнедеятельности организма, способах выделения ненужных веществ у беспозвоночных животных....
23 01 2026 21:19:38
 Спецкурс "Человек и человечество" занимает особое место при переходе на профильное обучение. Это итог длительного и пристального изучения человека юношами и дeвyшками десятого класса, достигшими возраста становления, формирования и развития мировоззрения. Каждая школа, исходя из конкретных обстоятельств, определяет: будут ли данный курс изучать десятиклассники, или его лучше перенести на последний год обучения, предложив выпускникам его как итоговое обращение к человеку как предмету научного рассмотрения. Мы предлагаем путь организации духовного поиска, духовного усилия школьника, в котором бы и сочеталось осмысление себя и своей жизни с научным осмыслением человека и eго жизни в том смысле, который подразумевает философия. ...
Спецкурс "Человек и человечество" занимает особое место при переходе на профильное обучение. Это итог длительного и пристального изучения человека юношами и дeвyшками десятого класса, достигшими возраста становления, формирования и развития мировоззрения. Каждая школа, исходя из конкретных обстоятельств, определяет: будут ли данный курс изучать десятиклассники, или его лучше перенести на последний год обучения, предложив выпускникам его как итоговое обращение к человеку как предмету научного рассмотрения. Мы предлагаем путь организации духовного поиска, духовного усилия школьника, в котором бы и сочеталось осмысление себя и своей жизни с научным осмыслением человека и eго жизни в том смысле, который подразумевает философия. ...
22 01 2026 10:58:32
Урок раскрывает понятие анализатор; формирует знания о функциях и строении анализаторов и их видах, о специфичности анализаторов, значении их частей в восприятии и анализе раздражений, действующих на человека, роли ощущений и восприятий в жизни человека, в познании окружающего мира....
21 01 2026 19:33:53
 При изложении курса "Биология" авторы используют три типа заданий, активизирующих субъектный опыт учащихся: выявление в содержании субъектного опыта детей признаков вводимого понятия; предоставление ученику на выбор определения понятия, в виде словесного описания, схемы или рисунка; при изучении, закреплении материала ученику предлагается раскрыть содержание изучаемого материала в виде рассказа, устного или письменного, схемы или рисунка по выбору ученика....
При изложении курса "Биология" авторы используют три типа заданий, активизирующих субъектный опыт учащихся: выявление в содержании субъектного опыта детей признаков вводимого понятия; предоставление ученику на выбор определения понятия, в виде словесного описания, схемы или рисунка; при изучении, закреплении материала ученику предлагается раскрыть содержание изучаемого материала в виде рассказа, устного или письменного, схемы или рисунка по выбору ученика....
20 01 2026 4:28:16
Урок обобщения и систематизации изученного материала по теме "Жизнь на земле". Цель урока: выявление уровня овладения учащимися системой знаний, опытом творческой деятельности....
19 01 2026 20:27:30
 Предлагаемый урок биологии является первым в цикле уроков, объединённых одной большой темой "Органы цветковых растений". В нём используется нестандартная форма начала урока, что активизирует мыслительную деятельность учащихся. Весь процесс изучения материала и проверка знаний, полученных на уроке, сопровождается мультимедийной презентацией....
Предлагаемый урок биологии является первым в цикле уроков, объединённых одной большой темой "Органы цветковых растений". В нём используется нестандартная форма начала урока, что активизирует мыслительную деятельность учащихся. Весь процесс изучения материала и проверка знаний, полученных на уроке, сопровождается мультимедийной презентацией....
18 01 2026 6:27:28
 Урок проводился по технологии проектного обучения, поскольку эта методика дает возможность более полного, всесторонне систематического исследования проблемы и разработки конкретного продукта (схема, модель, сценарий, отчет, презентация и т.п.), т.е. пpaктического результата. Как правило, проект - результат коллективной работы: более того предполагает на последнем этапе рефлексию - анализ, что дает возможность объективного оценивания работы....
Урок проводился по технологии проектного обучения, поскольку эта методика дает возможность более полного, всесторонне систематического исследования проблемы и разработки конкретного продукта (схема, модель, сценарий, отчет, презентация и т.п.), т.е. пpaктического результата. Как правило, проект - результат коллективной работы: более того предполагает на последнем этапе рефлексию - анализ, что дает возможность объективного оценивания работы....
17 01 2026 6:27:52
 Интеграция предметов гуманитарного и естественнонаучных циклов таит в себе огромные возможности для развития личности ребенка. Использование музыки и живописных произведений на уроке биологии затрагивает эмоциональную сферу ребенка, служит стимулом к творческой деятельности, расширяет сферу актуального знания. Дидактические особенности урока связаны с формированием опыта поисковой деятельности, включением опыта группового творческого поиска в широкий контекст личного опыта учащихся....
Интеграция предметов гуманитарного и естественнонаучных циклов таит в себе огромные возможности для развития личности ребенка. Использование музыки и живописных произведений на уроке биологии затрагивает эмоциональную сферу ребенка, служит стимулом к творческой деятельности, расширяет сферу актуального знания. Дидактические особенности урока связаны с формированием опыта поисковой деятельности, включением опыта группового творческого поиска в широкий контекст личного опыта учащихся....
16 01 2026 0:48:17
 Целью урока биологии в 8-м классе является активизация мыслительной деятельности учащихся, формирование осознанного интереса к предмету, выработка активности и самостоятельности. Урок направлен на развитие творческого потенциала учащихся, их логического и аналитического мышления, а также умения применять полученные знания на пpaктике.
...
Целью урока биологии в 8-м классе является активизация мыслительной деятельности учащихся, формирование осознанного интереса к предмету, выработка активности и самостоятельности. Урок направлен на развитие творческого потенциала учащихся, их логического и аналитического мышления, а также умения применять полученные знания на пpaктике.
...
15 01 2026 22:45:55
 Для создания условий по развитию и реализации интеллектуально-творческого потенциала, эрудиции, формированию коммуникативной культуры учащихся (7–9-х классов) проводится игра о жизни и деятельности великого русского ученого-энциклопедиста М.В. Ломоносова, посвященная его 300-летию....
Для создания условий по развитию и реализации интеллектуально-творческого потенциала, эрудиции, формированию коммуникативной культуры учащихся (7–9-х классов) проводится игра о жизни и деятельности великого русского ученого-энциклопедиста М.В. Ломоносова, посвященная его 300-летию....
14 01 2026 6:37:28
 Автор статьи представляет технологию развития критического мышления, где развивает у учащихся информационную и коммуникативную компетентность....
Автор статьи представляет технологию развития критического мышления, где развивает у учащихся информационную и коммуникативную компетентность....
13 01 2026 3:44:37
Представлен интеpaктивный проект для групповой работы с детьми разного возраста. Пособие может быть использовано в ДОУ, начальной школе, среднем звене. Варианты использования – диагностический материал для изучения или закрепления темы «Растения». Дети дают ответы на поставленные вопросы (в виде рисунков), цветными фишками на специальных карточках, что позволяет работать с группой детей....
12 01 2026 17:32:20
 Представлен нестандартный урок биологии "Метаморфозы", который может быть проведен в конце 10-го класса после изучения темы "Размножение и развитие организмов". Главная цель урока - формирование рефлексивных качеств, создание условий для осмысления школьниками собственных возможностей и стимулирование стремления меняться и развиваться. Некоторые идеи этого урока могут быть положены в основу классного часа для учащихся 9–11-х классов....
Представлен нестандартный урок биологии "Метаморфозы", который может быть проведен в конце 10-го класса после изучения темы "Размножение и развитие организмов". Главная цель урока - формирование рефлексивных качеств, создание условий для осмысления школьниками собственных возможностей и стимулирование стремления меняться и развиваться. Некоторые идеи этого урока могут быть положены в основу классного часа для учащихся 9–11-х классов....
11 01 2026 9:47:16
На уроке рассматриваются различные приспособительные особенности живых организмов и относительный хаpaктер адаптации, раскрывается механизм и роль приспособления. ...
10 01 2026 11:16:48
 Урок разработан с применением технологии развития критического мышления. Когда ребенок появляется на свет, все первым делом интересуются, сколько он весит. Но в первые минуты для врача важны другие параметры, позволяющие судить, здоров ли ребенок. Вот для такой быстрой оценки и применяют шкалу Апгар, названную так по имени её автора Виржинии Апгар. В чём причина наследственных заболеваний человека? Почему в некоторых семьях рождаются больные дети? Как помочь ребёнку родиться здоровым?
...
Урок разработан с применением технологии развития критического мышления. Когда ребенок появляется на свет, все первым делом интересуются, сколько он весит. Но в первые минуты для врача важны другие параметры, позволяющие судить, здоров ли ребенок. Вот для такой быстрой оценки и применяют шкалу Апгар, названную так по имени её автора Виржинии Апгар. В чём причина наследственных заболеваний человека? Почему в некоторых семьях рождаются больные дети? Как помочь ребёнку родиться здоровым?
...
09 01 2026 23:42:47
Цель урока: формировать умения узнавать изученных земноводных; обосновывать принадлежность к определенной систематической категории; обобщение и систематизация знаний о приспособленности земноводных к жизни в воде и на суше....
08 01 2026 13:35:45
 Данная программа реализуется в рамках экологического кружка "Олененок" начальной школы при Посольстве РФ в Шри-Ланке. Данная образовательная программа поможет младшему школьнику, посещающему школу в необычной для себя обстановке – в другой стране, быстрее адаптироваться к непривычным для себя условиям, а также научит ценить красоту природы различных стран....
Данная программа реализуется в рамках экологического кружка "Олененок" начальной школы при Посольстве РФ в Шри-Ланке. Данная образовательная программа поможет младшему школьнику, посещающему школу в необычной для себя обстановке – в другой стране, быстрее адаптироваться к непривычным для себя условиям, а также научит ценить красоту природы различных стран....
07 01 2026 22:34:54
 Желудок — вместительное расширение пищеварительного канала, в котором происходит дальнейшее переваривание пищи. Объем желудка взрослого человека 1,5-2л....
Желудок — вместительное расширение пищеварительного канала, в котором происходит дальнейшее переваривание пищи. Объем желудка взрослого человека 1,5-2л....
06 01 2026 18:38:18
 Данный урок является продолжением урока интегрированного плана указанной выше темы. Учащиеся обсуждают вкусовые качества мёда, виды мёда, диетологию продукта питания, его исторические факторы. На данном уроке показана интеграция биологии, истории, кулинарии, химии, диетологии. Учащиеся проводят различные исследования мёда. Особое место отводится правильному питанию по диетологии.
...
Данный урок является продолжением урока интегрированного плана указанной выше темы. Учащиеся обсуждают вкусовые качества мёда, виды мёда, диетологию продукта питания, его исторические факторы. На данном уроке показана интеграция биологии, истории, кулинарии, химии, диетологии. Учащиеся проводят различные исследования мёда. Особое место отводится правильному питанию по диетологии.
...
05 01 2026 20:39:48
 В наглядной форме (применение эксперимента) представлено детям такое сложное понятие как "регуляция", и это, несомненно, способствует лучшему усвоению нового материала, формированию познавательного интереса.
...
В наглядной форме (применение эксперимента) представлено детям такое сложное понятие как "регуляция", и это, несомненно, способствует лучшему усвоению нового материала, формированию познавательного интереса.
...
04 01 2026 5:13:23
Урок проводится с использованием ИКТ и технологии здоровьесбережения. Ученик становится на данном уроке субъектом учебного процесса, а учитель только управляет им....
03 01 2026 22:26:20
 Урок с моментами игрового и проблемного обучения. Обучение проходит в группах по 4 человека. На уроке используется много разных заданий: письма-шифровки, сделать пластилиновую модель цветка, черный ящик. На уроке много стихотворений, загадок, легенд. Урок сопровождается презентацией....
Урок с моментами игрового и проблемного обучения. Обучение проходит в группах по 4 человека. На уроке используется много разных заданий: письма-шифровки, сделать пластилиновую модель цветка, черный ящик. На уроке много стихотворений, загадок, легенд. Урок сопровождается презентацией....
02 01 2026 21:33:59
 Занятие с целью познакомить учащихся с жизнью деревьев и кустарников зимой, с особенностями их формы, окраски, ветвления, расположения почек, с приспособленностью растений к зимним условиям....
Занятие с целью познакомить учащихся с жизнью деревьев и кустарников зимой, с особенностями их формы, окраски, ветвления, расположения почек, с приспособленностью растений к зимним условиям....
01 01 2026 22:17:38
Благодаря этой проектной работе ребята узнают много нового и полезного для себя о воздухе, которым все мы дышим. Кроме того, в процессе проведения опыта учащиеся приобретают новые навыки исследовательской и самостоятельной работы, знакомятся с неизвестными им методиками проведения лабораторных опытов, проявляют к этому интерес. Проведению опытов предшествует подробный рассказ учителя о предстоящем исследовании, показ презентации, что расширяет кругозор ребят....
31 12 2025 10:47:31
 У учеников уже сформировано представление о покровах тела, опopно-двигательной системе, способах передвижения, дыхательной, пищеварительной, выделительной системе. И данная тема непосредственно связана с предыдущими темами, даёт представление о целостности организма и его эволюционном развитии. Предлагается дифференцированное домашнее задание.
...
У учеников уже сформировано представление о покровах тела, опopно-двигательной системе, способах передвижения, дыхательной, пищеварительной, выделительной системе. И данная тема непосредственно связана с предыдущими темами, даёт представление о целостности организма и его эволюционном развитии. Предлагается дифференцированное домашнее задание.
...
30 12 2025 11:17:45
 Валеологическая тетрадь разработана в помощь учителю для проведения проблемно-исследовательского урока здоровья и для мотивации учащегося по познанию себя. В разработке представлены разные задания (творческие, познавательные, экспериментальные, рефлексивные), валеологический самоанализ, паспорт здоровья, рекомендации ЗОЖ.
...
Валеологическая тетрадь разработана в помощь учителю для проведения проблемно-исследовательского урока здоровья и для мотивации учащегося по познанию себя. В разработке представлены разные задания (творческие, познавательные, экспериментальные, рефлексивные), валеологический самоанализ, паспорт здоровья, рекомендации ЗОЖ.
...
29 12 2025 17:33:33
 Изучение новой темы проходит в форме путешествия. Эффективность урока повышается за счёт применения информационно-коммуникативной и проектной технологий.
...
Изучение новой темы проходит в форме путешествия. Эффективность урока повышается за счёт применения информационно-коммуникативной и проектной технологий.
...
28 12 2025 12:57:30
 Интегрированный урок биологии и физкультуры не только раскрывает значение двигательной активности для организма, но и знакомит с бесценным опытом выживания в тяжелых для существования климатических условиях коренных народов Севера. Использование народных игр и состязаний на занятиях не только учит детей играть, но и знакомит их с обычаями и традициями....
Интегрированный урок биологии и физкультуры не только раскрывает значение двигательной активности для организма, но и знакомит с бесценным опытом выживания в тяжелых для существования климатических условиях коренных народов Севера. Использование народных игр и состязаний на занятиях не только учит детей играть, но и знакомит их с обычаями и традициями....
27 12 2025 3:47:19
 Расширяются знания о коже. Учащиеся учатся создавать мини-проекты, применяют элементы исследования....
Расширяются знания о коже. Учащиеся учатся создавать мини-проекты, применяют элементы исследования....
26 12 2025 11:45:14
Игра может использоваться во время внеклассных мероприятий по биологии. Она рассчитана на учеников 7–11-х классов классов. Игра не требует специальных знаний по биологии и проверяет, прежде всего кругозор участников. Игру может проводить как один ведущий, так и с помощниками....
25 12 2025 5:33:17
 Выделение — процесс, обеспечивающий выведение из организма образующихся в процессе жизнедеятельности вредных веществ, избытка воды и солей. В совокупности с...
Выделение — процесс, обеспечивающий выведение из организма образующихся в процессе жизнедеятельности вредных веществ, избытка воды и солей. В совокупности с...
24 12 2025 8:46:15
 Особенностью современного этапа обучения в школе является огромный поток информации, предлагаемой учащимся для усвоения. Как ориентироваться человеку в условиях «информационного бума»? Существует комплекс общеучебных приёмов и методов, способствующих эффективной работе учащихся с различной информацией. С некоторыми из них можно познакомиться на уроке информационной культуры....
Особенностью современного этапа обучения в школе является огромный поток информации, предлагаемой учащимся для усвоения. Как ориентироваться человеку в условиях «информационного бума»? Существует комплекс общеучебных приёмов и методов, способствующих эффективной работе учащихся с различной информацией. С некоторыми из них можно познакомиться на уроке информационной культуры....
23 12 2025 10:34:51
 Урок расширяет представление о здоровом образе жизни, формирует умение систематизировать и анализировать информацию, полученную на уроках биологии и из средств массовой информации. В ходе урока развивается творческое мышление, воспитывается чувство ответственности за свое здоровье и окружающих людей....
Урок расширяет представление о здоровом образе жизни, формирует умение систематизировать и анализировать информацию, полученную на уроках биологии и из средств массовой информации. В ходе урока развивается творческое мышление, воспитывается чувство ответственности за свое здоровье и окружающих людей....
22 12 2025 23:15:43
Предлагаемый урок по общей биологии разработан для учащихся 10-го профильного класса и направлен на активацию познавательной деятельности. К каждому этапу урока подобран интересный материал и демонстрируются кинофрагменты из диска "Биотехнология".
...
Предлагаемый урок по общей биологии разработан для учащихся 10-го профильного класса и направлен на активацию познавательной деятельности. К каждому этапу урока подобран интересный материал и демонстрируются кинофрагменты из диска "Биотехнология".
...
21 12 2025 6:55:21
 Урок по программе «Начальная школа XXI века» Н.Ф. Виноградовой выстроен в четком соответствии с методическими принципами деятельностного подхода данной системы. Урок служит созданию условий для ознакомления учащихся с кожей, её строением и значением....
Урок по программе «Начальная школа XXI века» Н.Ф. Виноградовой выстроен в четком соответствии с методическими принципами деятельностного подхода данной системы. Урок служит созданию условий для ознакомления учащихся с кожей, её строением и значением....
20 12 2025 17:43:39
 Использование ИКТ в обучении биологии позволяет создать условия для самостоятельного приобретения учащимся знаний за счет наглядности, создаваемой компьютером; реализации методики проблемного обучения с использованием ученических презентаций; автоматизации контроля результатов обучения, что позволяет индивидуально каждому ученику иметь полную и объективную информацию о ходе процесса освоения знаний в реальном временном масштабе; технических возможностей компьютера как дидактического средства обучения, позволяющего обеспечить эффективную реализацию развивающего обучения; развития способностей к творчеству и формирования психологической готовности к самореализации.
...
Использование ИКТ в обучении биологии позволяет создать условия для самостоятельного приобретения учащимся знаний за счет наглядности, создаваемой компьютером; реализации методики проблемного обучения с использованием ученических презентаций; автоматизации контроля результатов обучения, что позволяет индивидуально каждому ученику иметь полную и объективную информацию о ходе процесса освоения знаний в реальном временном масштабе; технических возможностей компьютера как дидактического средства обучения, позволяющего обеспечить эффективную реализацию развивающего обучения; развития способностей к творчеству и формирования психологической готовности к самореализации.
...
19 12 2025 0:39:59
 Урок-презентация разработан с использованием компьютерных технологий, основной теоретический материал отражен в презентации. Проведение урока в такой нестандартной форме способствует повышению мотивации учащихся. Основной целью урока-презентации является знакомство учащихся с особенностями строения животной и растительной клетки.
...
Урок-презентация разработан с использованием компьютерных технологий, основной теоретический материал отражен в презентации. Проведение урока в такой нестандартной форме способствует повышению мотивации учащихся. Основной целью урока-презентации является знакомство учащихся с особенностями строения животной и растительной клетки.
...
18 12 2025 11:29:21
 Предлагается четыре варианта задач по генетике. В каждом варианте три задачи по моногибридному скрещиванию, дигибридному скрещиванию и скрещиванию, сцепленному с полом.
...
Предлагается четыре варианта задач по генетике. В каждом варианте три задачи по моногибридному скрещиванию, дигибридному скрещиванию и скрещиванию, сцепленному с полом.
...
17 12 2025 23:12:11
 Интегрированный урок биологии и физической культуры соответствует учебной программе и содержит образовательную, развивающую и воспитательную задачи. Особенность урока состоит в одновременном участии двух педагогов-предметников. На уроке используются различные формы деятельности, учащиеся ведут активную, подвижную работу. Урок содержит материал не только из школьной программы, но и дополнительный....
Интегрированный урок биологии и физической культуры соответствует учебной программе и содержит образовательную, развивающую и воспитательную задачи. Особенность урока состоит в одновременном участии двух педагогов-предметников. На уроке используются различные формы деятельности, учащиеся ведут активную, подвижную работу. Урок содержит материал не только из школьной программы, но и дополнительный....
16 12 2025 22:51:54
Еще:
Биология, химия -1 :: Биология, химия -2 :: Биология, химия -3 :: Биология, химия -4 :: Биология, химия -5 :: Биология, химия -6 :: Биология, химия -7 :: Биология, химия -8 :: Биология, химия -9 :: Биология, химия -10 :: Биология, химия -11 :: Биология, химия -12 :: Биология, химия -13 :: Биология, химия -14 :: Биология, химия -15 :: Биология, химия -16 :: Биология, химия -17 ::






 Открытый урок по теме: "Обмен веществ и энергии у растений"
Открытый урок по теме: "Обмен веществ и энергии у растений"
 Урок изучения нового материала в 11-м классе по общей биологии по теме "Основные этапы (стадии) эволюции человека — антропогенеза"
Урок изучения нового материала в 11-м классе по общей биологии по теме "Основные этапы (стадии) эволюции человека — антропогенеза"
 Многообразие паукообразных. "Клещи — вредители культурных растений, паразиты животных и человека"
Многообразие паукообразных. "Клещи — вредители культурных растений, паразиты животных и человека"